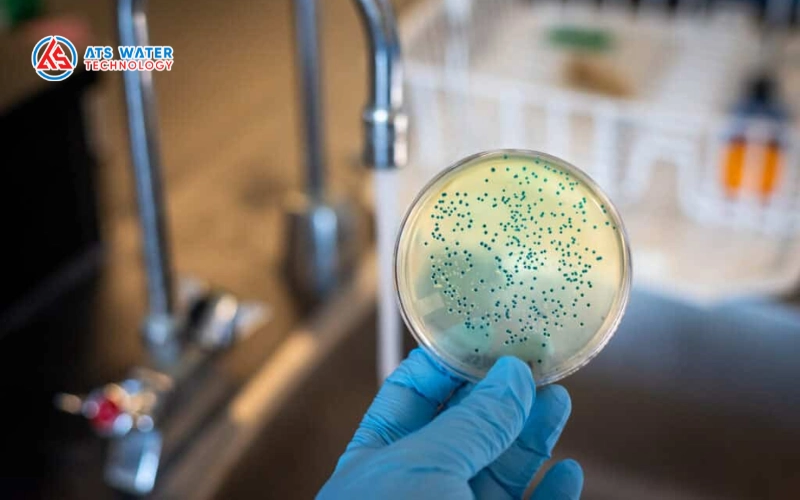
Phương pháp xác định coliform trong nước

Coliform trong nước là thông số vi sinh quan trọng dùng để đánh giá mức độ nhiễm bẩn phân và hiệu quả khử trùng trong hệ thống xử lý nước công nghiệp. Khi thông số này vượt giới hạn cho phép, hệ thống có thể đang gặp vấn đề về vận hành, tái nhiễm vi sinh hoặc suy giảm hiệu quả khử trùng. Vì vậy, kiểm soát coliform là yêu cầu quan trọng trong các ngành sản xuất có kiểm soát vi sinh nghiêm ngặt. Mời Quý khách theo dõi bài viết sau của ATS Water Technology để hiểu chi tiết hơn.
1. Các tác hại của coliform trong nước
Sự xuất hiện của coliform trong nước phản ánh tình trạng nhiễm bẩn hữu cơ có nguồn gốc từ phân, kéo theo nguy cơ tồn tại vi khuẩn, virus và ký sinh trùng gây bệnh. Trong hệ thống xử lý nước, đây là chỉ tiêu vi sinh quan trọng cần được kiểm soát nhằm đảm bảo an toàn vận hành và chất lượng nước đầu ra.
1.1 Trong sinh hoạt
Ở hệ thống cấp nước sinh hoạt, nếu chỉ tiêu coliform vượt quá mức 0 CFU/100mL trong nước uống (theo QCVN 01-1:2018/BYT), nguồn nước được xem là không đạt yêu cầu vệ sinh. Tác hại của coliform trong nước bao gồm:
- Gia tăng nguy cơ rối loạn tiêu hóa, tiêu chảy, viêm dạ dày – ruột.
- Nguy cơ nhiễm khuẩn đường ruột do các chủng E. coli gây bệnh.
- Ảnh hưởng đặc biệt nghiêm trọng đối với trẻ nhỏ, người cao tuổi và người suy giảm miễn dịch.
Do đó, kiểm soát và giảm coliform trong nước là yêu cầu bắt buộc trong thiết kế và vận hành hệ thống xử lý nước cấp.
1.2 Trong sản xuất công nghiệp
Trong lĩnh vực thực phẩm, đồ uống, dược phẩm và chế biến thủy sản, coliform trong nước là thông số đánh giá mức độ đảm bảo vệ sinh công nghệ. Nếu không kiểm soát tốt, có thể dẫn đến:
- Ô nhiễm vi sinh chéo vào sản phẩm, khiến sản phẩm không đạt tiêu chuẩn an toàn thực phẩm.
- Ảnh hưởng đến chất lượng sản phẩm và thời hạn bảo quản.
- Tăng chi phí khử trùng bổ sung và rủi ro thu hồi sản phẩm.
Đối với các hệ thống xử lý nước công nghiệp tuần hoàn (cooling tower, RO, CIP), tải lượng vi sinh cao còn làm gia tăng nguy cơ hình thành màng sinh học (biofilm), gây suy giảm hiệu suất trao đổi nhiệt và tăng chi phí vận hành.

2. Phương pháp xác định coliform trong nước
Để đảm bảo tuân thủ tiêu chuẩn coliform trong nước, các phòng thí nghiệm và bộ phận QA/QC cần áp dụng đúng phương pháp xác định coliform trong nước theo quy trình chuẩn.
Các phương pháp phổ biến gồm:
- Phương pháp màng lọc (Membrane filter method): Lọc mẫu qua màng 0,45 µm, sau đó ủ trên môi trường M-Endo hoặc LES Endo agar ở 35-37°C trong 22-24 giờ. Kết quả biểu thị bằng CFU/100 mL. Phương pháp này phù hợp cho giám sát định lượng coliform trong hệ thống nước công nghiệp.
- Thạch VRBA (Violet Red Bile Agar): Sử dụng chỉ thị pH và muối mật để phát hiện vi khuẩn lên men lactose; bước xác nhận thường thực hiện trên môi trường BGLB (Brilliant Green Lactose Bile Broth)có quan sát sinh khí.
- Thạch EMB (Eosin Methylene Blue): Phân biệt phân biệt vi khuẩn lên men lactose mạnh; E. coli thường tạo khuẩn lạc có ánh kim xanh đặc trưng.
- Phương pháp PCR: Khuếch đại gen chỉ thị của coliform (ví dụ gen mã hóa beta-galactosidase), cho độ nhạy cao và rút ngắn thời gian phân tích, phù hợp trong môi trường yêu cầu kiểm soát vi sinh nghiêm ngặt.
Việc lựa chọn phương pháp phụ thuộc vào mục tiêu giám sát: kiểm tra định kỳ, xác nhận sau CIP/SIP, hoặc điều tra nguyên nhân tái nhiễm vi sinh.
Xem thêm: 5 Cách xử lý nước nhiễm Ecoli hiệu quả
3. Cách xử lý coliform trong nước cấp sinh hoạt và sản xuất
Khi phát hiện coliform trong nước vượt ngưỡng cho phép, cần xác định rõ nguồn nhiễm vi sinh và lựa chọn công nghệ khử trùng phù hợp với mục đích sử dụng. Trong hệ thống xử lý nước cấp sinh hoạt và nước công nghiệp, giải pháp thường bao gồm tổ hợp tiền xử lý – lọc tinh – khử trùng, nhằm đảm bảo hiệu quả loại bỏ vi sinh và duy trì ổn định chất lượng nước đầu ra.
3.1. Khử trùng bằng Clo (Cl₂/NaOCl)
Khử trùng bằng clo là phương pháp phổ biến trong hệ thống cấp nước nhờ khả năng duy trì dư lượng khử trùng trong mạng lưới phân phối. Clo oxy hóa màng tế bào và enzyme nội bào, làm bất hoạt vi khuẩn coliform.
Trong thực tế vận hành:
- Duy trì clo dư tự do 0,2-0,5 mg/L tại điểm cuối mạng lưới phân phối (tùy quy chuẩn áp dụng).
- Đảm bảo giá trị CT (nồng độ × thời gian tiếp xúc) đủ để đạt hiệu suất diệt khuẩn yêu cầu.
- Kiểm soát pH trong khoảng 6,5-7,5 để tối ưu hiệu quả khử trùng.
Đây là một trong số những cách xử lý coliform trong nước sinh hoạt và nước sản xuất thực phẩm quy mô lớn; tuy nhiên cần kiểm soát sản phẩm phụ khử trùng (Disinfection By-Products – DBPs) như THMs.

3.2. Khử trùng bằng tia UV
Tia UV bước sóng 254 nm phá hủy cấu trúc DNA/RNA của vi khuẩn, làm mất khả năng nhân lên của coliform. Đây là giải pháp được sử dụng rộng rãi trong hệ thống nước tinh khiết, nước RO sau xử lý và dây chuyền sản xuất thực phẩm – dược phẩm.
Yêu cầu kỹ thuật quan trọng:
- Độ truyền tia UV (UVT) ≥ 85% để đảm bảo liều chiếu xạ hiệu quả.
- Liều UV phổ biến 30-40 mJ/cm² cho mục tiêu kiểm soát coliform trong nước.
- Không tạo sản phẩm phụ hóa học, nhưng không duy trì dư lượng khử trùng trong hệ thống.
UV phù hợp trong hệ thống kín và chất lượng nước ổn định, nơi nguy cơ tái nhiễm vi sinh được kiểm soát tốt.

3.3. Khử trùng bằng Ozone (O₃)
Ozone là tác nhân oxy hóa mạnh, có khả năng phá hủy nhanh cấu trúc tế bào vi khuẩn và oxy hóa các hợp chất hữu cơ. Ozone trong nước có thể tạo gốc hydroxyl (-OH) với khả năng oxy hóa rất mạnh. Trong hệ thống nước công nghiệp yêu cầu chất lượng cao (nước đóng chai, nước công nghệ), ozone giúp giảm coliform trong nước đồng thời cải thiện màu và mùi.
Đặc điểm kỹ thuật:
- Thời gian tiếp xúc ngắn, hiệu suất diệt khuẩn cao.
- Không để lại dư lượng khử trùng lâu dài trong hệ thống.
- Yêu cầu thiết bị tạo ozone và hệ thống an toàn khí ozone.
Giải pháp này phù hợp khi cần nâng cao chất lượng vi sinh của nước và hạn chế hóa chất tồn dư.

3.4. Giải pháp tích hợp: tiền xử lý – lọc tinh – khử trùng
Trong thực tế thiết kế hệ thống xử lý nước công nghiệp, chỉ khử trùng đơn lẻ có thể không đủ nếu tải lượng vi sinh ban đầu cao. Do đó, mô hình xử lý thường bao gồm:
- Keo tụ – lắng – lọc cát áp lực để giảm độ đục và hàm lượng chất hữu cơ trong nước.
- Lọc tinh cartridge 1-5 µm trước công đoạn khử trùng.
- Kết hợp Clo/UV/Ozone tùy theo mục tiêu chất lượng nước và yêu cầu vận hành.
Giải pháp tích hợp giúp nâng cao hiệu suất loại bỏ vi sinh, giảm nguy cơ tái nhiễm và đảm bảo đạt tiêu chuẩn coliform trong nước theo yêu cầu vận hành.

Bảng so sánh các phương pháp xử lý coliform trong nước:
| Tiêu chí | Clo (Cl₂/NaOCl) | UV (Tia cực tím) | Ozone | Hệ thống tích hợp |
|---|---|---|---|---|
| Cơ chế tác động | Oxy hóa màng tế bào vi khuẩn | Phá hủy DNA/RNA | Oxy hóa mạnh, phân hủy tế bào | Giảm tải vi sinh + khử trùng |
| Duy trì dư lượng | Có | Không | Không | Tùy cấu hình |
| Hiệu quả diệt khuẩn | Cao khi đạt giá trị CT phù hợp | Cao đối với vi khuẩn và virus | Rất cao, thời gian tiếp xúc ngắn | Rất cao do nhiều lớp bảo vệ |
| Ứng dụng điển hình | Cấp nước sinh hoạt, sản xuất thực phẩm quy mô lớn | Nước RO, nước tinh khiết, dược phẩm | Nước đóng chai, nước công nghệ chất lượng cao | Xử lý nước công nghiệp, yêu cầu nghiêm ngặt |
| Lưu ý kỹ thuật | Kiểm soát pH, CT và sản phẩm phụ (THMs) | Yêu cầu UVT cao, độ đục thấp; không chống tái nhiễm | Chi phí đầu tư cao, cần hệ thống an toàn khí | Thiết kế theo tải lượng vi sinh thực tế |
4. Các câu hỏi thường gặp về coliform trong nước
Nguyên nhân xuất hiện coliform trong nước là gì?
Chủ yếu do nước nguồn bị nhiễm phân từ nước thải sinh hoạt, chất thải chăn nuôi hoặc rò rỉ hệ thống thoát nước. Ngoài ra, sự tái nhiễm trong bể chứa, đường ống phân phối hoặc hệ thống xử lý nước vận hành không ổn định cũng có thể làm tăng chỉ tiêu coliform.
Nước có coliform có uống được không?
Nếu coliform trong nước uống vượt ngưỡng cho phép, thì nguồn nước đó không được phép sử dụng trực tiếp cho mục đích ăn uống.
Chỉ tiêu coliform trong nước uống bao nhiêu là an toàn?
Theo quy chuẩn QCVN 01-1:2018/BYT của Bộ Y tế Việt Nam, chỉ tiêu Coliform trong nước uống trực tiếp phải bằng 0 CFU/100ml. Điều này có nghĩa là trong 100 mL mẫu nước không được phát hiện vi khuẩn coliform.
Làm sao để loại bỏ coliform trong nước?
Có thể áp dụng các phương pháp khử trùng như clo hóa, tia UV hoặc Ozone. Trong hệ thống xử lý nước công nghiệp, các giải pháp này thường được kết hợp với tiền xử lý và lọc tinh nhằm giảm tải vi sinh và đảm bảo hiệu quả khử trùng ổn định. Để giảm coliform trong nước bền vững, cần kiểm soát cả nguồn ô nhiễm và quy trình vận hành hệ thống.,.
Như vậy, coliform trong nước là thông số vi sinh quan trọng phản ánh mức độ nhiễm bẩn và nguy cơ an toàn sức khỏe. Trong hệ thống xử lý nước công nghiệp, việc kiểm soát đúng chỉ tiêu, lựa chọn phương pháp xác định phù hợp và áp dụng công nghệ khử trùng hiệu quả là yếu tố quyết định để đảm bảo chất lượng nước đầu ra đạt tiêu chuẩn kỹ thuật và vận hành ổn định lâu dài. Quý khách có thể liên hệ với ATS Water Technology để được tư vấn chi tiết.
CÔNG TY TNHH CÔNG NGHỆ NƯỚC ATS
- Trụ sở chính: 54/18 Bùi Quang Là, P. An Hội Tây, TP. HCM
- Chi nhánh: 77 ĐHT10B, P. Đông Hưng Thuận, TP. HCM
- Tư vấn hỗ trợ: (028) 6258 5368 – (028) 6291 9568
- Email: info@atswatertechnology.com
- Mạng xã hội: Facebook | LinkedIn | YouTube
- Liên hệ nhanh: Zalo Official | Telegram | WhatsApp
























































































































